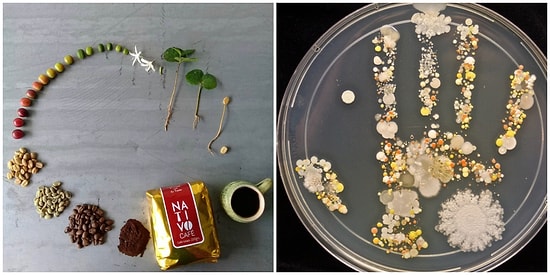
Hayatınızda En Az Bir Kez Görmeniz Gereken Benzerine Az Rastlanabilecek Fotoğraflar

Tarot Falına Göre 3 Haziran Pazartesi Günü Senin İçin Nasıl Geçecek?
Günlük tarot falına bakmak ve neler olacak hemen öğrenmek ister misin? Günlük olarak hazırladığımız tarot falı ile birlikte falsız kalmayacaksın : )Bakalım 3 Haziran Pazartesi senin için nasıl geçecek? Bugün senin için nasıl geçecek merak ediyorsan, tarot falına başlayalım!